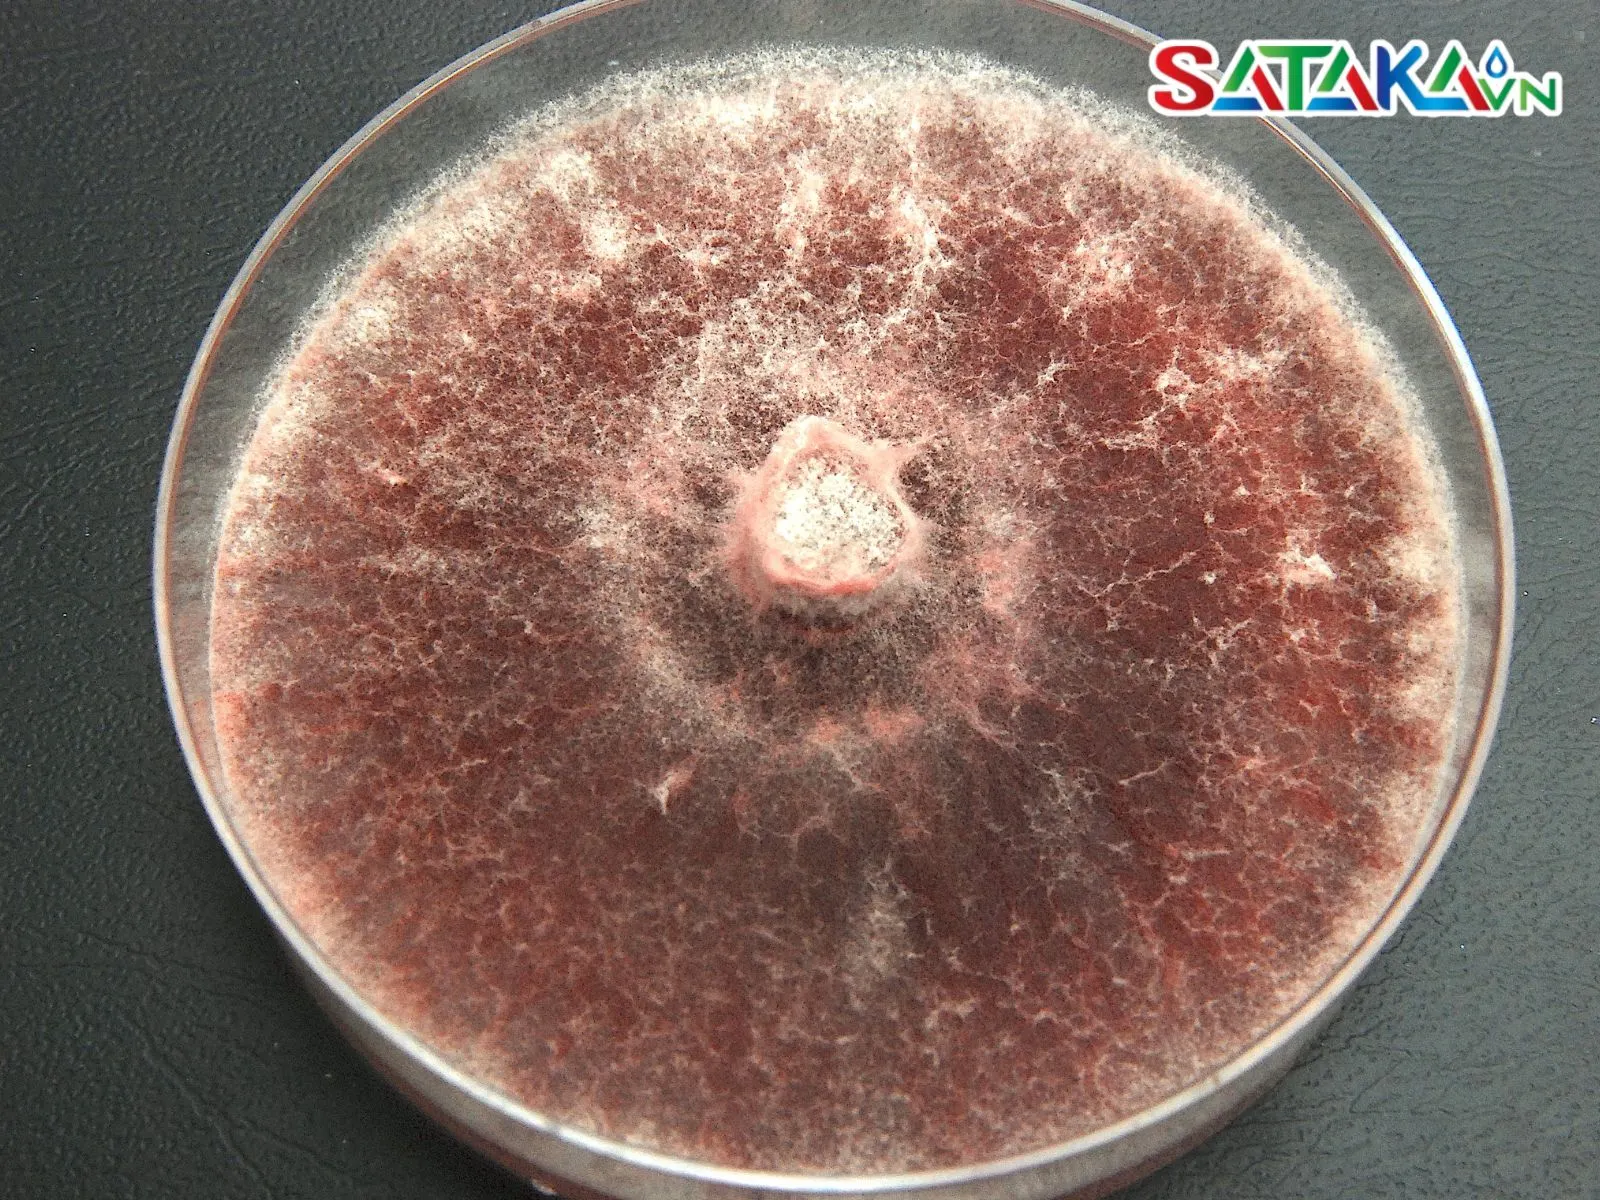

Root rot on coffee trees is a serious disease that causes root rot and weakens the tree, leading to reduced yield and fruit quality. Prevention and early treatment are very important to protect coffee gardens.
Root collar rot is a significant threat to the health and productivity of coffee plants. In recent years, this disease has shown a tendency to spread, causing considerable damage to farmers. How dangerous is root collar rot, and what are the best ways to identify and prevent it? Let’s explore the details with Sataka.
Root collar rot is a common and dangerous disease affecting coffee plants, especially in plantations with prolonged wet conditions. When a coffee plant is infected, the base near the ground shows symptoms such as dark spots, rot, and peeling bark.

Coffee root rot disease
The disease severely affects the base and roots of the plant, weakening it and potentially leading to death if not treated promptly. It can spread quickly, impacting entire coffee gardens if effective prevention measures are not in place.
The primary causes of root collar rot are two types of fungi: Rhizoctonia solani and Fusarium spp. These fungi thrive in moist soils with poor drainage, particularly when temperatures range from 25°C to 30°C. Coffee gardens with long-standing waterlogging or low soil pH provide ideal conditions for fungal growth.
Rhizoctonia Solani fungus
In addition, mechanical damage to plants during weeding, fertilization, or soil tilling creates entry points for fungi to attack. Another critical factor is the imbalanced use of fertilizers, especially the overuse of nitrogen, which weakens the coffee plant and reduces its disease resistance.
The symptoms of root collar rot are easily identifiable if coffee growers pay attention. The collar area, where the stem meets the soil, exhibits black rot and peeling bark. As the disease progresses, the infection spreads to the roots and the lower stem, impairing the plant's ability to absorb nutrients.

The shell is peeling
Affected plants display yellowing and falling leaves, accompanied by stunted growth. In the later stages, when most of the roots are destroyed, the plant gradually dies. Notably, the disease can spread between plants through root systems or via contaminated irrigation water and unsterilized gardening tools.
Root collar rot not only reduces yield but also significantly impacts the quality of coffee cherries. Fruits from infected plants are often small, shriveled, discolored, and fail to meet export standards, resulting in severe economic losses.

The coffee tree withered
Additionally, once the disease appears in a coffee garden, farmers face increased costs for purchasing pesticides, soil treatment, and additional labor. These expenses raise production costs and reduce business efficiency. If left uncontrolled, the disease can spread to neighboring areas, lowering the competitiveness of coffee gardens in the market.
Prevention is always the top priority in pest management. For root collar rot, selecting coffee varieties with disease resistance is an essential first step. High-quality coffee varieties not only resist diseases but also ensure stable yields.

Maintain stable Ph level
Improving soil conditions is also critical. The soil should have good drainage, a stable pH level (5.5 - 6.5), and avoid waterlogging around the roots. During cultivation, applying organic fertilizers combined with biological products helps balance the soil microbiome and boosts the plant's resistance to diseases.
Regular garden sanitation is necessary to remove infected plant residues. Gardening tools should also be sterilized before use to prevent the spread of fungal pathogens.
When plants are infected, prompt action is required. The use of pesticides containing active ingredients such as Tricyclazole, Metalaxyl, or Propiconazole is essential for controlling the disease, especially when it has spread widely.
However, farmers must strictly adhere to application guidelines regarding dosage and spraying intervals to avoid adverse effects on the coffee plants and prevent overuse.
In addition to chemical treatments, applying organic fertilizers combined with biological products helps restore soil structure and promote the growth of beneficial microorganisms, aiding plant recovery. Removing and destroying heavily infected parts of the plant is also necessary to stop the disease from spreading.

Destroy infected plants
Root collar rot is a significant challenge that requires a combination of integrated management measures, including prevention, early detection, and timely treatment. Coffee growers must increase their awareness of the importance of disease prevention and invest in cultivation practices to maintain stable coffee yields and quality. Sataka hopes this article provides valuable information to farmers!